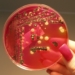
Canada’s Public Health Agency says Salmonella Outbreak Hits 6 Provinces, Dozens sick and Two Dead

A heated conversation is turning hateful, and potentially violent.Several neighbors living in the Rincon Hill area of San Francisco say they have received death threats for donating to a GoFundMe page…
Photo Credit: NBC Bay Area
This story is from The SFGate. Read the rest of this News story at http://www.nbcbayarea.com/news/Opponents-of-Homeless-Center-Planned-for-San-Franciscos-Embarcadero-Receive-Death-Threats-508195591.html.